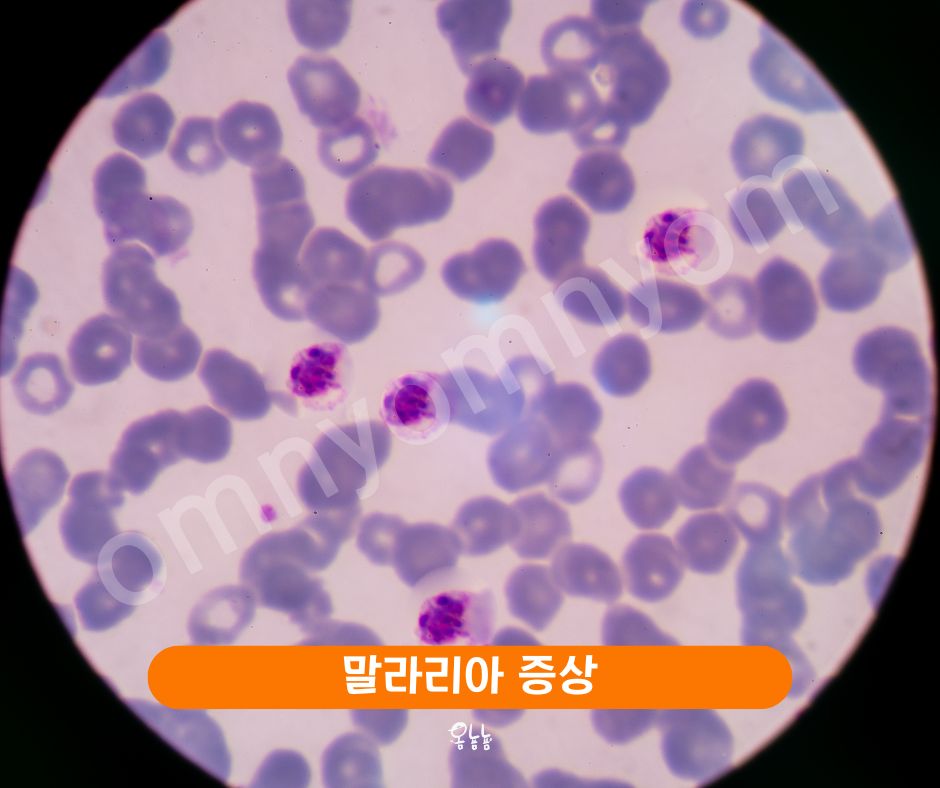
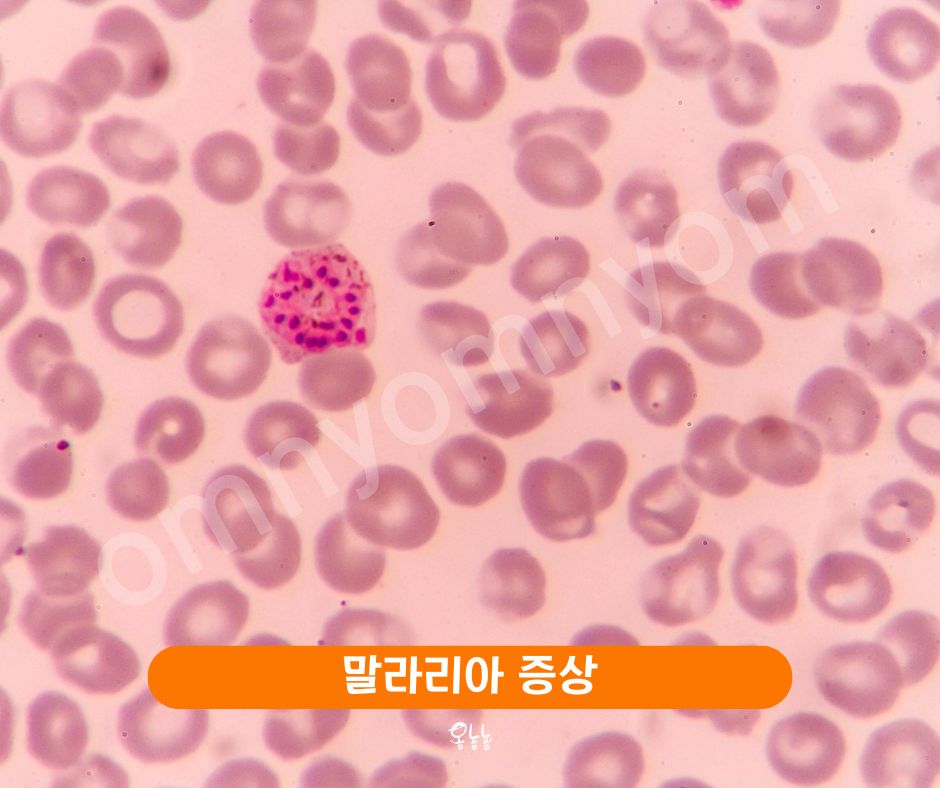
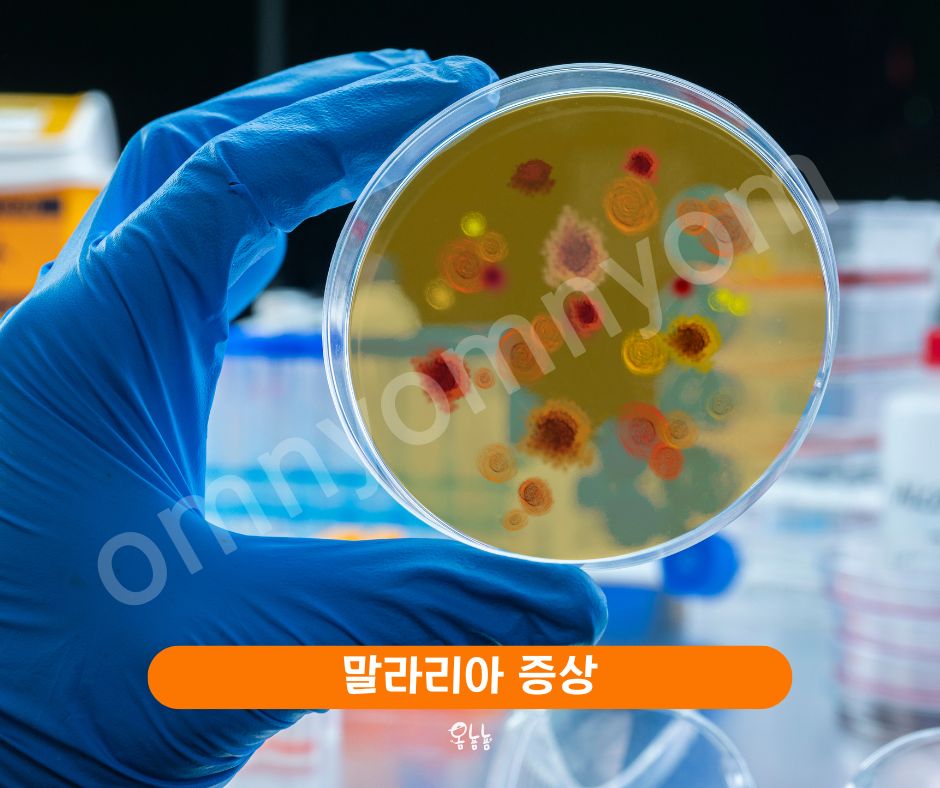

우리나라 특히 경기 북부 지역인 파주, 연천, 김포 등에서 거주하고 계시다면 여름에 더욱 주의해야할 질병이 있는데요. 바로 말라리아 입니다. 말라리아는 전 세계적으로 매년 수백만 명의 생명을 앗아가는 심각한 질병입니다. 말라리아 증상, 진단 방법, 그리고 예방 및 치료에 대해 상세히 알아보겠습니다.

말라리아는 모기에 의해 전염되는 감염병으로, 주로 열대 및 아열대 지역에서 발생합니다. 말라리아는 플라스모디움(Plasmodium)이라는 기생충에 의해 발생하며, 모기에 물린 후 혈류를 통해 간으로 이동해 증식을 시작합니다.






우리나라에서 말라리아가 발생하는 지역, 특히 특정 지역에서는 주의가 필요합니다. 주요 발생 지역은 다음과 같습니다.
이 지역들을 방문하거나 거주하는 경우, 모기 물림을 피하기 위한 예방 조치가 매우 중요합니다.
말라리아 증상은 감염 후 7일에서 30일 사이에 나타나며, 초기 증상은 일반적으로 감기나 독감과 비슷하여 간과되기 쉬운 것이 문제입니다. 말라리아가 발생할 수 있는 지역에 여행 다녀오신 후 아래와 같은 말라리아 증상이 나타난다면 '좀 쉬면 괜찮겠지'라고 생각하지 마시고 꼭 의료기관을 방문하세요.






말라리아 증상이 의심된다면 의료기관을 찾아 신속한 진단을 받는 것이 매우 중요합니다. 진단 방법은 다음과 같습니다.
말라리아를 예방하는 가장 효과적인 방법은 모기에게 물리지 않도록 하는 것입니다. 예방 방법은 다음과 같습니다.
말라리아 증상은 적절한 치료를 받으면 완치가 가능합니다. 주요 치료 방법은 다음과 같습니다.
SUMMARY
말라리아는 빠른 진단과 치료가 중요한 질병입니다. 말라리아 증상을 인지하고, 예방 조치를 철저히 하면 말라리아로 인한 위험을 크게 줄일 수 있습니다. 특히 우리나라의 말라리아 발생 주의 지역에서는 모기 방지 대책을 철저히 준수해야 합니다. 올 여름 건강한 삶을 유지하는 데 도움이 되길 바랍니다.
더 알아보기 : 고혈압에 좋은 음식과 DASH 식단 │브랜 효능 식이섬유가 중요!

이 글이 도움이 되셨다면
"구독"하고
"공유"해 주세요.
[이 페이지는 여러분에게 유용하다고 판단되는 제품의 링크를 포함하고 있습니다. 링크를 통해 구매하시면, 이에 따른 일정액의 수수료를 제공받습니다]
비트 효능과 비트즙의 건강 효과
비트 효능과 비트즙의 건강 효과빨간 뿌리채소인 비트는 심장 건강을 걱정하는 분들, 운동 능력을 향상시키고자 하는 분들, 체중을 관리하고자 하는 분들, 그리고 피부 건강을 개선하고자 하는
food.omnyomnyom.com
스피루리나 효과와 추천
건강을 위한 새로운 보충제를 찾고 계신가요? 그렇다면 스피루리나를 한 번 고려해보세요. 스피루리나는 많은 사람들이 '슈퍼푸드'라고 부르는 고단백, 고영양 식품으로, 다양한 건강 효과를 제
food.omnyomnyom.com
면역력 높이는 음식과 도움되는 영양제는?
면역력 높이는 음식으로 식단을 바꾸자아픈건 딱 질색이잖아요. 그런데 최근 들어 자주 피로감을 느끼거나 잦은 감기와 같은 작은 질병에 쉽게 걸려 매일이 힘들게 느껴지실 때가 있으신가요?
food.omnyomnyom.com